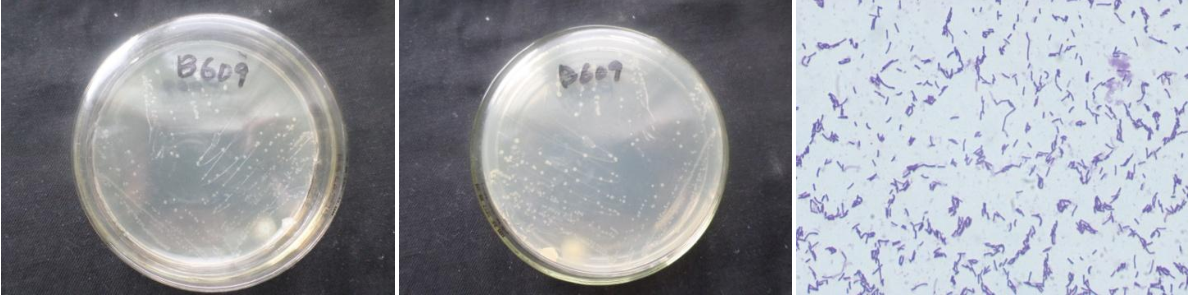

Loading...
| StrainNO | B609 |
| Classification | Gracilibacillus |
| 16s rDNA sequence | CGGGCAGTGGCGGGTGCTAATACATGCAAGTCGAGCGCGGGAAGCTTGTCTGACCCCTTCGGGGTGACGCGAGTGGAACGAGCGG CGGACGGGTGAGTAACACGTGGGCAACCTGCCTGTAAGACTGGGATAACTCCGGGAAACCGGGGCTAATACCGGATAATACATTG CTTCGCATGAAGCAATGTTGAAAGATGGCTTTTAGCTATCACTTACAGATGGGCCCGCGGCGCATTAGCTAGTTGGTAAGGTAAT GGCTTACCAAGGCAACGATGCGTAGCCGACCTGAGAGGGTGATCGGCCACACTGGGACTGAGACACGGCCCAGACTCCTACGGGA GGCAGCAGTAGGGAATCTTCCGCAATGGACGAAAGTCTGACGGAGCAACGCCGCGTGAACGAAGAAGGTTTTCGGATCGTAAAGT TCTGTTGTTAGGGAAGAACAAGTACCGTTCGAATAGGGCGGTACCTTGACGGTACCTATCGAGGAAGCCCCGGCTAACTACGTGC CAGCAGCCGCGGTAATACGTAGGGGGCAAGCGTTGTCCGGAATTATTGGGCGTAAAGCGCGCGTAGGCGGTTTCTTAAGTCTGAT GTGAAATCTTGCGGCTCAACCGCAAGCGGCCATTGGAAACTGAGGAACTTGAGTGCAGAAGAGGAGAGCGGAATTCCACGTGTAG CGGTGAAATGCGTAGATATGTGGAGGAACACCAGTGGCGAAGGCGGCTCTCTGGTCTGTAACTGACGCTGAGGTGCGAAAGCGTG GGGAGCGAACAGGATTAGATACCCTGGTAGTCCACGCCGTAAACGATGAGTGCTAGGTGTTAGGGGGTTTCCGCCCCTTAGTGCT GCAGTTAACGCATTAAGCACTCCGCCTGGGGAGTACGGCCGCAAGGCTGAAACTCAAAAGGATTTGACGGGGGTCCCGCACAAGC CGGTGGAGCATTGTGGTTAATCGAGGCAACGCGGAGAAACCTTACAAGTTCTTGACATCTTCGGATGTCCTAGAAGATAGGGAGG TTCCGTCGGGACGAATGACAGGTGGTGCATGGGTTGTCGTCAGCTCGGGTCTGGAAGATTGTGGGTTAAGTCCGCTACGATGCCA AACCATGAATCTGATTGCCAGCATTAGCTGGTCTCTAGTAACTGCTCGGTACAAACCGATAGGTGATGACTCAAGTCTATCACAT GACGCCTTTAAAGCATCGTGGTGCT |
| Strain Morphology Photos | |
| Morphological Description | Colony round;clam white;edge serrated;Flattened;have concentric rings;multifold;bright;sticky;Waxed:Rod;having spore;Bacteriophage telogen |